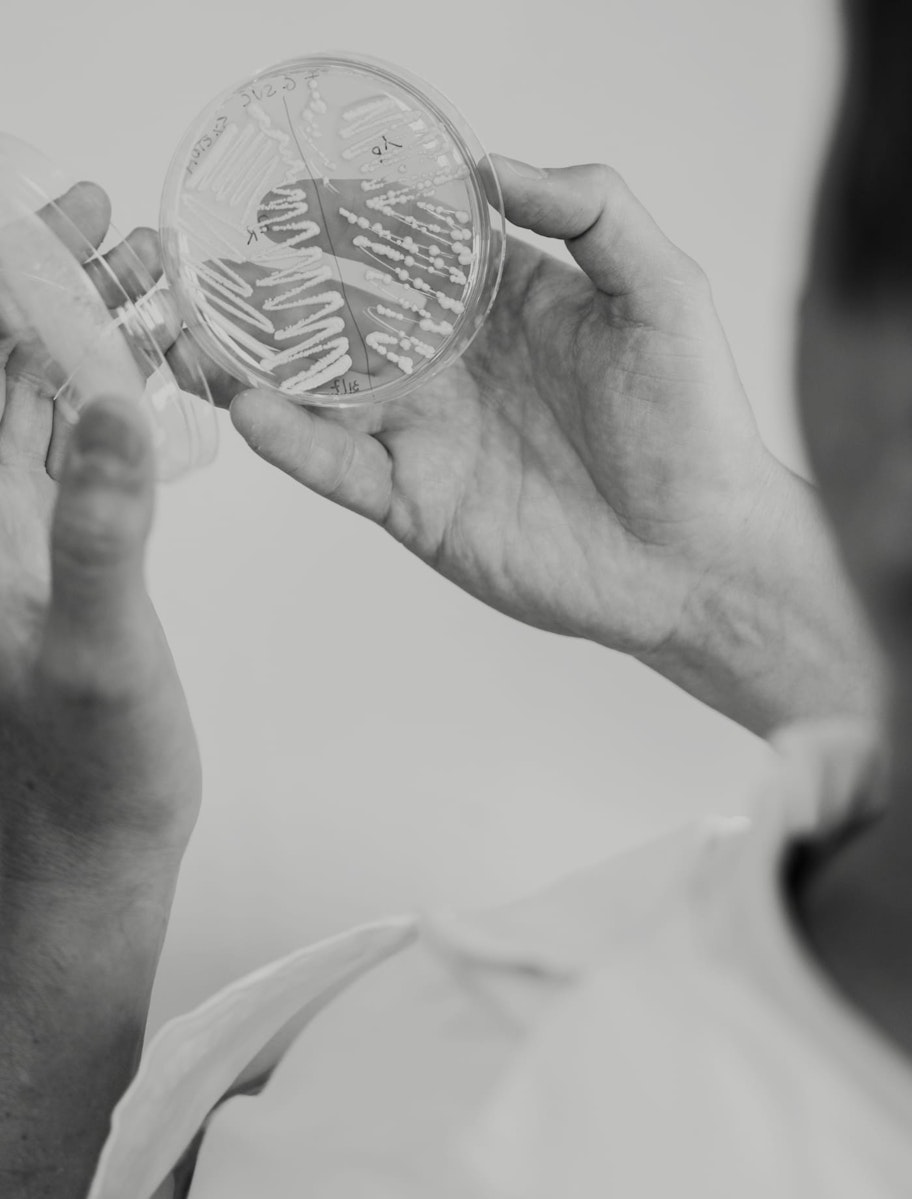

AIRDOM
REBRANDING
Brand identity, Strategy
UN’IDENTITÀ RINNOVATA CHE CONFERMA LA LEADERSHIP DEL BRAND NEL MONDO DELLO SPORTSWEAR E DELLO STREETWEAR.


LA SFIDA
Il rebranding era una mossa strategica necessaria, ma al tempo stesso una sfida cruciale: occorreva rinnovare il marchio mantenendo intatto il legame con la sua essenza e la sua community.
Trasformare questa transizione in un’opportunità era necessario per rafforzare il posizionamento premium di Airdom, preservandone i valori e proiettandolo verso il futuro con una comunicazione forte e coerente su tutti i touchpoint.
OUTCOME
Definizione di un’identità visiva rinnovata e sviluppo di un concept di comunicazione capace di raccontare i valori distintivi di Airdom, rafforzare il legame con la community e consolidare il posizionamento del brand nel mercato sportswear e streetwear.
Implementazione di una strategia omnicanale per il lancio del nuovo brand, coinvolgendo touchpoint digitali e fisici in modo integrato.
Ottimizzazione della presenza digitale attraverso landing page e campagne Google Ads per tutelare la transizione dal precedente naming al nuovo.
OUTPUT
Un rebranding completo che coinvolge ogni aspetto della comunicazione e dell'identità del brand, garantendo coerenza tra tutti i canali online e offline.
Brand Sprint: un processo collaborativo attivato in azienda per ricercare e definire l’identità di Airdom e il nuovo concept di comunicazione.
Naming: creazione di un nuovo nome.
Strategia omnicanale: azioni coordinate di teasing e lancio su social, sito web, app e punti vendita, rafforzate da una campagna Google Ads per gestire la transizione dal vecchio nome.
Materiali di comunicazione: poster, packaging e capsule collection per rappresentare la nuova identità anche nei negozi fisici, creando un’esperienza di brand immersiva e riconoscibile.
Campagna di comunicazione: il concept “See You in the Hoop” per consolidare la nuova identità e connettere la community attraverso contenuti dedicati e prodotti brandizzati.
Il Nuovo naming
Trovare la parola giusta per raccontare non solo ciò che l'azienda è oggi, ma soprattutto ciò che aspira a diventare. Da questa visione nasce Airdom: un ponte tra la storia già scritta e quella ancora da scrivere.
LA STRATEGIA DIGITALE
Per Airdom, abbiamo scelto di anticipare l'evoluzione del brand con una campagna teaser. L'obiettivo è mantenere l'attenzione alta e coinvolgere la community durante il renaming.
Online, la strategia sugella l’abbandono di "NESS", anticipando l’arrivo di una nuova identità, con lo stesso messaggio diffuso su social, adv, sito e newsletter.
Il debutto di Airdom sui social avviene con un video teaser che, in linea con la campagna, ha svelato il nuovo nome con un effetto di scoperta graduale.
Abbiamo creato una landing page per intercettare le ricerche legate al naming precedente, e lanciato una campagna Google Search per promuovere il nuovo brand. L'iniziativa ha coinvolto migliaia di utenti, dando visibilità al processo di rebranding.
Attraverso una campagna di branding su Meta Ads, Airdom riafferma i propri valori, celebrando il basket come gioco di squadra e stile di vita. Inclusione, sostenibilità e valorizzazione dei talenti guidano il nuovo concept.
See You in the Hoop è un modo metaforico per darsi appuntamento sul campo da basket ma è anche e soprattutto un invito rivolto all’intera community, a incontrarsi proprio lì, a canestro, dove ambizioni e traguardi trovano il loro centro.
L’IMPATTO OFFLINE
La strategia digitale ha coinvolto la community con iniziative in-store. Nei negozi di Milano e Roma, poster con il messaggio “There’s something new in the Air” hanno introdotto la nuova identità.
Materiali dedicati, come folder personalizzati e una linea di abbigliamento, hanno reso tangibile il rebranding, creando un’esperienza coerente tra online e offline per clienti e community.
Oltre a presentare ufficialmente il nuovo nome, l’evento Airdom Act 1 è stata un’ottima occasione per:
Presentare la linea di abbigliamento e accessori a marchio Airdom
Presentare e distribuire il nuovo merchandising del brand ( adesivi, spille, bag...) con la creazione di una bag dedicata ai primi member della Airdom Fam che si sono iscritti all’evento.
Presentare ufficialmente il configuratore Airdom Custom per la realizzazione delle divise personalizzate

TECNOLOGIE E STRUMENTI
Abbiamo utilizzato una piattaforma di Customer Engagement, Sales Manago, per la personalizzazione dei percorsi cliente su più canali, consentendo al brand di migliorare la crescita e la fidelizzazione.
Inoltre abbiamo integrato la strategia di marketing attraverso le piattaforme pubblicitarie come Meta Ads e Google Ads per ottimizzare le campagne e rafforzare la visibilità del nuovo brand.
TIMELINE - 8 MESI

RISULTATI
Il processo di rebranding ha portato a un significativo rafforzamento dell'identità di Airdom, evidenziato da un aumento della brand recognition e dell'engagement della community esistente.
La nuova strategia di comunicazione omnicanale ha permesso di valorizzare l'evoluzione del brand mantenendone gli elementi distintivi storici, mentre la presenza digitale è stata potenziata attraverso un'integrazione seamless di tutti i touchpoint: dall’eCommerce all’app, fino al configuratore 3D.
Questo approccio integrato ha garantito una presenza innovativa pienamente allineata con le ambizioni del brand, rafforzando il legame con la community esistente.
3D Video Credit: Vice3D
Video Credit: BSA Studio
Photo Credit: Francesca Di Fazio
Senti di passare inosservato?
È tempo di farti notare.
Se la tua azienda non riesce ad attirare l'attenzione, trasmettere il valore della tua proposta e lasciare il segno, è il momento di ripensare alla tua brand image. Ti possiamo aiutare a distinguerti dalla concorrenza e a costruire una connessione solida con il tuo pubblico.